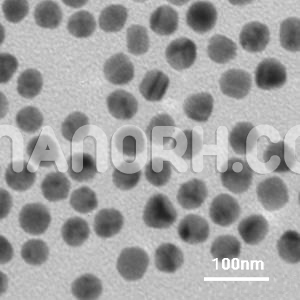
Gold Silicon Oxide Core-Shell Gold Silicon Oxide Core-Shell Nanoparticles

| Gold Silicon Oxide Core-Shell Nanoparticles | |
| Product No | NRE-16044 |
| CAS No. | 7440-57-5 / 7631-86-9 |
| Formula | Au/SiO2 |
| APS | <100nm (can be customized) |
| Shape | Spherical |
| Purity | 99.9% |
| Core | Gold |
| Shell | Silicon |
| Appearance | Powder |
| Boiling Point | NA |
Gold Silicon Oxide Core-Shell Nanoparticles
Applications:
Biomedical Applications
Drug Delivery: Au-SiO₂ core-shell nanoparticles are used extensively as drug delivery vehicles. The gold core offers high surface area and the ability to load hydrophobic drugs, while the silicon oxide shell provides a stable, biocompatible platform that can be functionalized with targeting agents (e.g., antibodies, peptides) for selective drug delivery. The core-shell design allows for controlled release of drugs, reducing side effects and improving therapeutic efficacy. The silica shell can also be used to encapsulate multiple drugs or therapeutic agents, enabling combination therapy.
Imaging and Diagnostics: The optical properties of the gold core (e.g., surface plasmon resonance (SPR), photoacoustic imaging) make Au-SiO₂ nanoparticles excellent candidates for imaging in diagnostic applications. The gold core can provide strong contrast in imaging modalities such as CT scans, X-ray imaging, and optical imaging. The silica shell improves the stability and biocompatibility of the nanoparticles, making them suitable for use in living organisms. Furthermore, these nanoparticles can be employed in fluorescence imaging and biosensing for real-time monitoring of biological processes.
Cancer Therapy (Theranostics): In theranostics, which combines both diagnostic and therapeutic approaches, Au-SiO₂ nanoparticles are particularly valuable. The gold core’s ability to absorb near-infrared (NIR) light allows for photothermal therapy (PTT), where the nanoparticles generate localized heat upon exposure to NIR light to destroy cancer cells. The silica shell can be functionalized to deliver chemotherapeutic drugs to the target area, allowing for a combination of photothermal and chemotherapy. This dual function can enhance the treatment’s specificity and effectiveness while minimizing off-target effects.
Sensing and Biosensing
Biosensors: Au-SiO₂ core-shell nanoparticles are widely used in biosensing applications due to their ability to interact with biological molecules on their surface. The gold core exhibits plasmonic properties, which make it highly sensitive to changes in its local environment, such as the binding of a specific biomolecule. The silica shell can be easily modified with biomolecules like antibodies, aptamers, or enzymes, making these nanoparticles suitable for real-time detection of biomolecules such as proteins, DNA, RNA, and small molecules. They are often employed in SPR-based biosensors, where the binding of target molecules leads to a measurable change in the nanoparticle’s optical properties.
Environmental Monitoring: Gold-silica nanoparticles are also used in environmental sensing for detecting pollutants, heavy metals, and toxic gases. The plasmonic properties of gold enable the detection of low concentrations of pollutants, while the silica shell can be modified to selectively bind to certain chemicals or contaminants, making these nanoparticles ideal for environmental monitoring and contaminant detection.